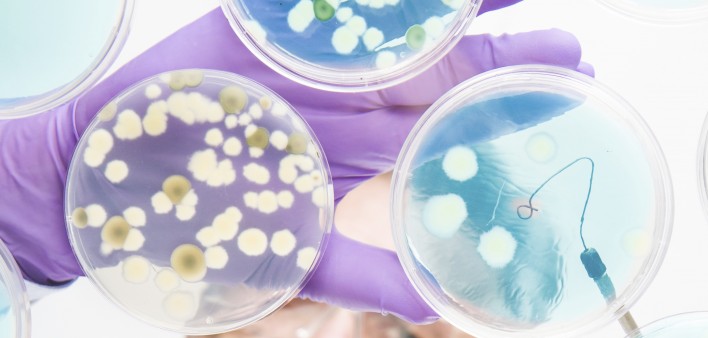

The population of bacteria under the foreskins of uncircumcised men may affect their risk of contracting HIV through heterosexual sex. The increased risk of transmission of the virus is specifically related to anaerobic bacteria that thrive in low-oxygen environments.
Publishing their findings in the journal mBio, researchers studied penile swabs taken from beneath the foreskins of uncircumcised heterosexual men participating in a two-year study in Rakai, Uganda. They looked at swabs from all 46 men who contracted HIV during the study as well as 136 men who remained HIV-negative and served as a control group.
“This study is the first to suggest that the bacteria colonizing the penis can be an independent risk factor for HIV in men,” Cindy Liu, MD, MPH, PhD, the paper’s first author and an assistant research professor of environmental and occupational health at the Milken Institute School of Public Health at George Washington University. “Having more oxygen-intolerant bacteria was associated with increased HIV risk.”
The investigators measured the levels of four types of anaerobic bacteria found in the swabs: Prevotella, Dialister, Finegoldia and Peptoniphilus. They concluded that members of a group of uncircumcised men who have a level of such bacteria 10-fold higher than a comparison group have an estimated 54 to 63 percent higher risk of contracting HIV through heterosexual sex.
In theory, such bacteria increase the risk of HIV acquisition by spurring a reaction in the body that sends to the surface of the penis the very type of immune cells that the virus targets. The investigators found that having a higher level of anaerobic penile bacteria was linked to a higher production of cytokines, which are a part of the immune system that serve as a kind of recruiter for pathogen-fighting immune cells.
In the future, researchers may develop treatments that alter the penile microbiome, reducing the recruitment of immune cells to the surface of the penis and thus lowering the risk of contracting HIV.
To read a press release about the study, click here.
To read the study abstract, click here.

4 Comments
4 Comments